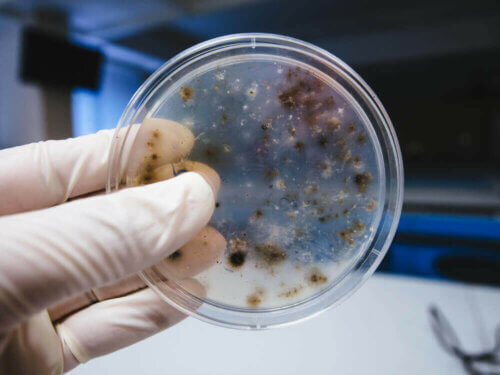

Que sont les germes et où se trouvent-ils ?


Rédigé et vérifié par Le biologiste Samuel Antonio Sánchez Amador
Vous êtes-vous déjà demandé ce que sont les germes ? Le mot « germe » a plusieurs significations selon le contexte dans lequel on l’utilise. En biologie, on le définit comme la partie reproductrice d’une plante qui germe pour grandir, par exemple. Métaphoriquement, on peut aussi dire qu’un germe est l’initiateur de quelque chose, d’un mouvement.
Ainsi, nous jugeons bon d’expliquer dans cet article la définition et l’emplacement des germes en tant qu’agents biologiques pathogènes. Si vous voulez en apprendre plus sur ce passionnant monde microscopique, continuez à nous lire.
Que sont les germes ?
On définit un germe comme n’importe quel micro-organisme capable de produire une maladie ou de faire du mal à son hôte, qu’il s’agisse d’un être humain, d’un animal ou d’un végétal. Il existe quatre types fondamentaux de germes, et nous les détaillerons dans cet article.
Bactéries
Les bactéries sont des organismes procaryotes (c’est-à-dire unicellulaires), qui mesurent quelques microns et ont des formes variées.
Selon le programme Earth Microbiome Project, il y plus d’un billion d’espèces de bactéries sur la planète. Il n’est donc pas exagéré de dire qu’il s’agit du ciment essentiel à tout écosystème. Selon leur morphologie, les bactéries peuvent se diviser en plusieurs types :
- Cocci, de forme sphérique et selon la quantité d’individus qui forment la structure (diplocoques, tétracoques et streptocoques)
- Bacillus, en forme de bâtonnet
- Formes hélicoïdales : vibrions, spirilles et spirochètes
Les bactéries peuvent être immobiles ou avoir des capacités motrices, grâce à des cils ou des flagelles. Selon la méthode de détection, basée sur la nature de la paroi externe de leur structure, elles peuvent être à Gram négatif ou à Gram positif. Ces micro-organismes peuvent être des êtres vivants libres ou des agents pathogènes.
Selon la définition stricte du terme, seules les bactéries pathogènes seraient considérées comme des germes.

Virus
Les virus sont encore plus petits et plus simples que les bactéries. Ces germes sont des chaines d’ADN ou d’ARN (simples ou multiples) revêtues par une couche protéique qui leur donne leur forme tridimensionnelle.
Il existe près de 5000 espèces de virus connues, et leur reproduction est impossible s’ils n’envahissent pas d’hôte. Les virus séquestrent les cellules du malade et leur fonctionnement, s’y auto-répliquant pour continuer à étendre la maladie.
Cet article va vous intéresser : Le cycle de reproduction des virus
Champignons, protozoaires et autres
Dans le but de maintenir cet article le plus concis et informatif possible, nous détaillerons le reste des germes ou agents pathogènes ci-dessous :
- Les protozoaires sont des micro-organismes unicellulaires, tout comme les bactéries. Cependant, ils sont différents de celles-ci car ils sont d’une grande taille et qu’ils présentent une complexité morphologique. Ils vivent dans des milieux humides, et peuvent être des parasites. Un exemple très clair de cette catégorie est le protozoaire causant le paludisme
- Les champignons, à la différence des protozoaires, sont un taxon d’organismes pluricellulaires complexes, dans lesquelles on trouve les moisissures, les levures et les producteurs de champignons. Certains d’entre eux peuvent infecter les animaux comme les plantes, formant un mycélium (ou « blanc de champignon ») dans les cellules du tissu touché et s’en nourrissant
- Il existe aussi d’autres germes plus difficiles à décrire, comme les viroïdes ou les prions, qui sont des molécules d’ARN ou protéines mal configurées à capacité infectieuse
Pour en apprendre plus à ce sujet : Les principaux agents pathogènes de l’été
Où y-a-t-il le plus de germes ?
La question correcte serait : y-a-t-il un endroit sans germes sur Terre ? Les micro-organismes dominent tous les milieux, et nous entourent à chaque instant (et se trouvent même dans notre corps).
Mais, comme dans le sens strict du terme un germe est un pathogène pour d’autres êtres vivants, on délimitera sa prévalence dans certains endroits publics :
- Piscines et parcs aquatiques : c’est ici qu’ils se réunissent tous. Les protozoaires et les champignons ont besoin d’humidité, et les virus d’une forte densité d’hôtes. N’importe quel site humide et aggloméré est un bon bouillon de culture pour des colonies de germes
- Argent, caddies de supermarché, superficies de toilettes publiques, etc : de nombreux virus et bactéries restent sur des superficies pendant un certain laps de temps. Par conséquent, plus il y a de personnes en contact avec un instrument, plus l’instrument est susceptible d’avoir une charge en germes élevée
- Corps humain : même si cela semble surprenant, toutes les bactéries présentes dans notre corps pèsent approximativement un à deux kilos. Celles-ci sont surtout présentes dans notre système digestif. Certes, ces bactéries n’entreraient pas dans la définition stricte de germe, car elles ne sont pas pathogènes pour nous. Par contre, l’être humain présente de hautes charges virales quand il est atteint de maladies, comme la grippe ou le rhume
Comme nous pouvons le constater, le terme de germes ne suffit pas si nous voulons englober tous les nombreux micro-organismes qui sont responsables de pathologies chez les êtres vivants. Ils ont tous une chose en commun : ce sont des êtres microscopiques qui profitent de l’existence des autres pour survivre, provoquant toute sorte de maladies chez leurs hôtes.
Toutes les sources citées ont été examinées en profondeur par notre équipe pour garantir leur qualité, leur fiabilité, leur actualité et leur validité. La bibliographie de cet article a été considérée comme fiable et précise sur le plan académique ou scientifique
- Broniatowski DA, Klein EY, Reyna VF. Germs are germs, and why not take a risk? Patients’ expectations for prescribing antibiotics in an inner-city emergency department. Med Decis Making. 2015;35(1):60‐67. doi:10.1177/0272989X14553472
-
National Research Council (US) Committee to Update Science, Medicine, and Animals. Science, Medicine, and Animals. Washington (DC): National Academies Press (US); 2004. A Theory of Germs. Available from: https://www.ncbi.nlm.nih.gov/books/NBK24649/
-
InformedHealth.org [Internet]. Cologne, Germany: Institute for Quality and Efficiency in Health Care (IQWiG); 2006-. What are microbes? 2010 Oct 6 [Updated 2019 Aug 29]. Available from: https://www.ncbi.nlm.nih.gov/books/NBK279387/
Ce texte est fourni à des fins d'information uniquement et ne remplace pas la consultation d'un professionnel. En cas de doute, consultez votre spécialiste.